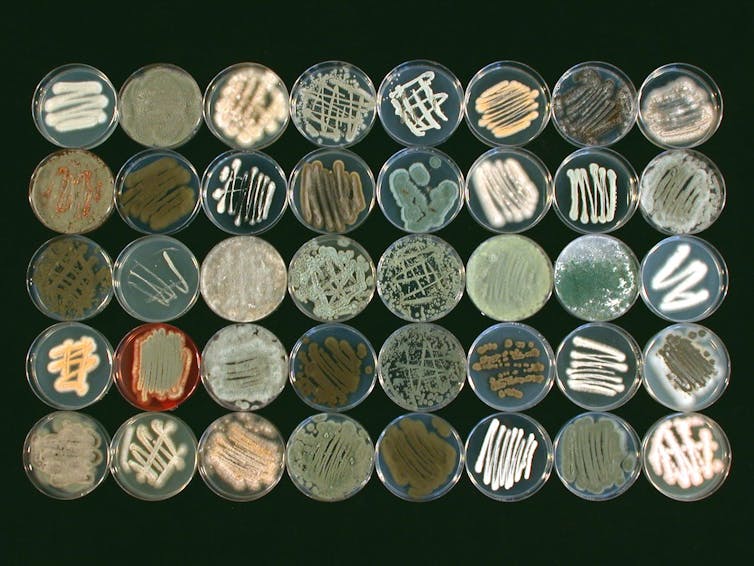

Combien de champignons sont menacés d’extinction ? Pour répondre à cette question il faut vite en poser plusieurs autres : combien y a-t-il d’espèces de champignons en tout ? Qu’est-ce qu’un champignon, au juste ?
Et de découvrir, au passage, le monde aussi mystérieux que fascinant de ce règne ni végétal ni animal.
Les champignons sont partout et pourtant si mal connus. Ce ne sont ni des plantes ni des animaux. Ainsi, à côté du règne végétal et du règne animal, ils forment leur propre règne qui abrite une grande richesse d’espèces et de formes de vie. Ils jouent un rôle fondamental dans le fonctionnement des écosystèmes et pour l’être humain. Beaucoup de champignons participent par exemple à la décomposition de la matière organique, qui permet le recyclage de la matière en rendant les nutriments à nouveau accessibles aux plantes.
Un grand nombre d’entre eux s’associent également à des plantes en échangeant directement des nutriments pour un bénéfice mutuel. D’autres sont comestibles ou sont utilisés pour la production de boissons et d’aliments grâce à la fermentation. Certains ont même la capacité d’extraire des polluants du sol par un processus que l’on nomme bioremédiation ou mycoremédiation.

Dire combien d’espèces de champignons existent est une tâche difficile, car une grande partie n’est pas visible à l’œil nue. Beaucoup ne sont pas cultivables en laboratoire, ce qui rend encore plus complexe leur identification et description. Aujourd’hui, on connaît 155 000 espèces, mais certaines études estiment cependant qu’entre 2 millions et 4 millions d’espèces de champignons restent encore à découvrir et à identifier.
Un champignon, c’est quoi ?
Mais un champignon, qu’est-ce que c’est au juste ? Vaste question ! Le mot « champignon » est en fait souvent associé à l’image de la structure sortant du sol, avec son pied et son chapeau, ou accolée à un arbre, en forme d’oreille. Cependant, la majorité des espèces fongiques ne produisent pas ce type de structures. Chez les espèces qui en sont dotées, cette partie du champignon contient les spores sexuées. Son nom savant est le « sporophore ». En anglais, cette distinction apparaît, puisqu’il existe deux mots distincts : « mushroom », qui décrit les sporophores, soit donc cette partie présente sur certains champignons, et « fungus » qui décrit toutes les espèces appartenant à la classe Fungi.
Le reste du corps du champignon est rarement visible et il est bien particulier. C’est un réseau microscopique formé d’hyphes. Ces hyphes sont des cellules très allongées qui forment des sortes de tunnels de quelques microns de diamètre. Leur ensemble ramifié, nommé « mycélium », se développe dans le substrat sur lequel il pousse (dans le sol, sur le bois, sur les feuilles mortes…) pour y chercher et en extraire des nutriments.
Un champignon est donc un organisme unicellulaire (comme les levures) ou pluricellulaire qui se caractérise par une paroi cellulaire contenant de la chitine et des cellules reproductives (qu’on appelle spores) non mobiles.
Ce n’est pas une plante pour de nombreuses raisons : les champignons ne font pas de photosynthèse et n’ont pas de sève. La paroi cellulaire des plantes est composée de cellulose, et non de chitine.
S’intéresser aux champignons, c’est entrer dans l’infiniment petit mais aussi l’infiniment grand. Ainsi, à la fin des années 1980, des scientifiques découvraient en Oregon (nord-ouest des États-Unis) un spécimen d’Armillaria gallica vieux de près de 2 500 ans dont le mycélium s’étend sur plus de 37 hectares.
Une liste rouge qui s’allonge
Pour savoir maintenant combien de champignons sont menacés, il faut regarder du côté de la liste rouge de l’UICN (Union internationale pour la conservation de la nature). C’est l’inventaire le plus complet, répertoriant les espèces et leur état de conservation. Sa première édition est publiée en 1964. Elle ne comporte alors que des mammifères et des oiseaux rares.
Concernant les champignons en France, il faudra attendre 2024 pour que le premier inventaire des champignons menacés soit publié par le comité français de l’UICN.
Le 27 mars dernier, la liste rouge mondiale a, elle, été actualisée pour inclure le statut de 1 300 espèces de champignons. Nous sommes loin des 155 000 espèces connues, mais les premières évaluations restent préoccupantes avec 411 espèces de champignons menacées d’extinction, soit près d’un tiers des espèces recensées.
Bien que ce nombre soit important, il est primordial de rappeler que, dû au manque d’informations, les espèces qu’on a estimées les plus vulnérables ont été répertoriées en premier afin de faciliter le développement de projets de conservation.
Certaines de ces espèces sont rares, et n’ont été détectées que dans des zones géographiques très restreintes. En France hexagonale et en Corse, la liste rouge s’étend à 79 espèces qui sont menacées et 39 espèces sous le statut de « quasi menacées ». Cette liste inclut des lichens, dont Buellia asterella, classée en danger critique, qui n’a pas été repérée sur le territoire depuis 1960. On retrouve aussi des champignons décomposeurs, comme c’est le cas de Laccariopsis mediterranea qui pousse dans les dunes côtières de la Méditerranée et dont les populations sont en fort déclin (d’approximativement 30 %, ces trente dernières années).
Des espèces forment des relations symbiotiques avec les plantes : les plantes fournissent des sucres issus de la photosynthèse, tandis que les champignons apportent des nutriments provenant du sol. Ces espèces sont aussi menacées ; par exemple, Cortinarius prasinocyaneus, champignon associé au chêne et au charme. En France, il est uniquement répertorié sur cinq sites.
Des menaces bien identifiées, les répercussions beaucoup moins
Si le monde des champignons reste à beaucoup d’égards mal connu, tout comme le nombre exact d’espèces vulnérables, une chose reste quant à elle certaine : les menaces qui pèsent sur ces espèces sont bien identifiées. On trouve le changement dans l’utilisation des terres, notamment avec la destruction d’habitats et la déforestation, les pollutions liées à l’urbanisation et à l’agriculture (fertilisation déraisonnée et pesticides). Le changement climatique s’additionne maintenant aux autres menaces qui pèsent sur les champignons.
Leur perte pourrait entraîner des modifications dans le fonctionnement des écosystèmes. De nombreux champignons participent à la décomposition, un processus important dans le cycle des nutriments. Dans le cas des espèces qui forment des relations symbiotiques avec les plantes, ces associations peuvent être très spécifiques avec des champignons ne pouvant s’associer qu’avec une ou deux espèces d’arbres. C’est le cas de Geomorium gamundiae, en Argentine, et de Destuntzia rubra, en Chine et au Japon, des espèces en danger critique d’extinction à cause de la déforestation menaçant leur plante hôte.
Mais l’inverse pourrait également se produire : si le champignon était menacé, cela entraînerait des conséquences néfastes pour leur hôte.
La conservation des champignons : encore du chemin à faire
Contrairement à la faune et à la flore, il n’existe pas de plan de conservation pour les espèces fongiques.
Les connaissances sur ces organismes étant trop limitées pour qu’ils fassent partis des lois environnementales quand celles-ci ont émergé, ils ont été les grands oubliés des projets de conservation. Actuellement, le seul rempart de protection pour ces espèces est la protection et la conservation des habitats, par des directives tel que le réseau Natura 2000 dans l’Union européenne.
Des initiatives existent cependant pour promouvoir la recherche, la connaissance et l’inclusion des champignons dans la législation. De par leur ubiquité et leurs rôles dans l’écosystème, les champignons forment un règne tout aussi important que les plantes ou les animaux.
Il est donc primordial de les prendre en compte pour protéger les écosystèmes en intégrant la faune, la flore… et la fonge.

Coline Deveautour, Enseignante-Chercheuse en Écologie microbienne des sols, UniLaSalle
Cet article est republié à partir de The Conversation sous licence Creative Commons. Lire l’article original.